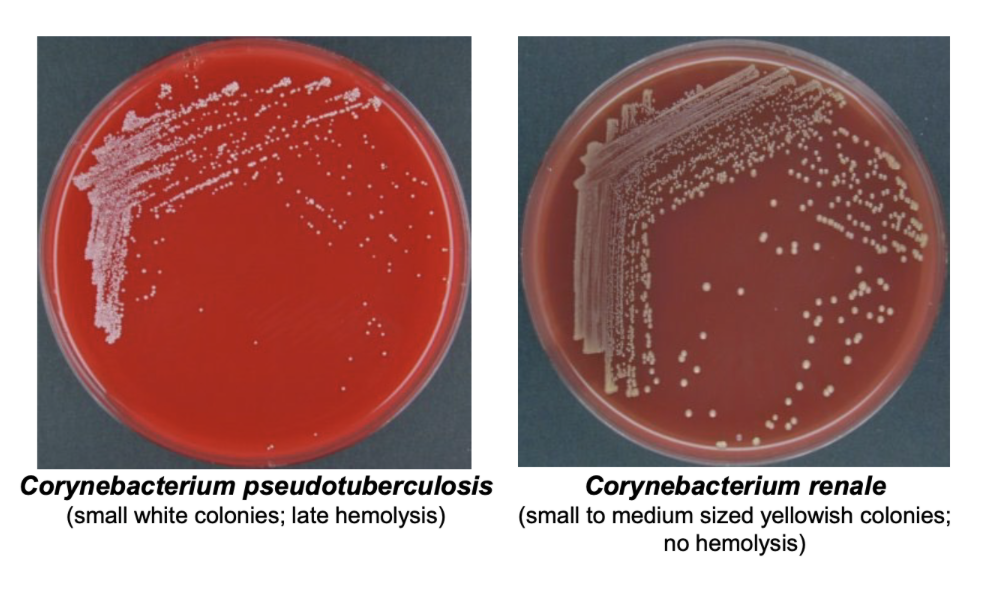
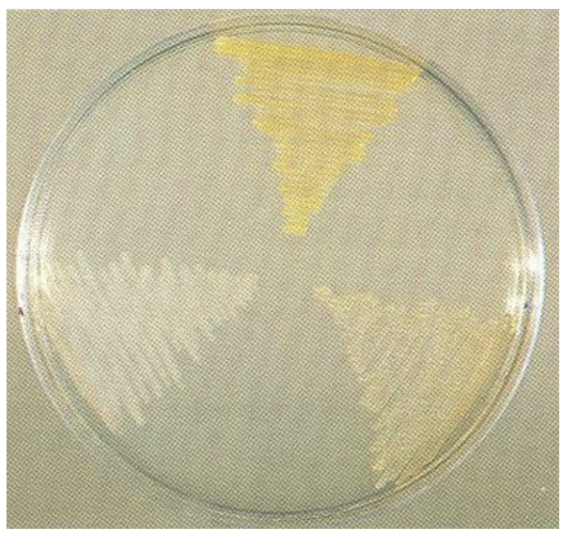
term image

L15 - EAE and Corynebacterium
1/37
There's no tags or description
Looks like no tags are added yet.
Name | Mastery | Learn | Test | Matching | Spaced | Call with Kai |
|---|
No analytics yet
Send a link to your students to track their progress
38 Terms
What pathogen causes Enzootic Abortion of Ewes (EAE)?
Chlamydia abortus
What species does Chlamydia abortus target?
Sheep, cattle, pig, goats
What type of of bacteria is Chlamydia abortus?
Spherical
Unable to synthesize own ATP → Energy Parasite
Intracellular Parasite
Cell walls lack peptidoglygan → have LPS instead
What types of disease does Chlamydia abortus cause?
Respiratory, Enteric and Reproductive
How is Chlamydia abortus transmitted?
Fecal-oral
Placentas and uterine discharge
Ingestion
When does Chlamydia abortus typically cause abortion in ewes?
Early pregnancy
Late pregnancy will usually not abort, but potential to abort in next pregnancy
When do most EAE outbreaks occur?
The breeding season after introduction of infection to the flock (typically due to replacement ewes being affected)
EAE Pathogenesis
First signs @ 90 days gestation
Chlamydia abortus targets trophoblast layer of placenta → inflammation → thrombotic vasculitis and tissue necrosis
Abortion results from reduced fetal-materal exchange → lack of placental endocrine fxn and immune protection from dam
Symptoms of EAE
Abortion during late pregnancy
Birth of premature, weak lambs
Necrosis of cotyledons
Edema of adjacent intercotyledonary tissue
Dirty pink uterine exudate
Do sheeps affected with Chlamydia abortus have decreased fertility?
No, only attacks placenta
How is EAE diagnosed?
Aborted lambs
Evidence of necrotic placentitis
Elevated EBs in placental smears
MZN Staining → can be confused with Coxiella burnetti

How is EAE treated?
Antibiotics → doesn’t eliminate infection, ewes can still shed at parturition
Long-acting oxytetracycline
How is EAE controlled?
Isolate aborted ewes for 2-3 weeks
Clean birthing areas
Long-acting oxytetracycline to ewes who haven’t lambed yet
Live attenuated vaccine → prior to breeding
Inactivated vaccine → pregnant animals
Is Chlamydia abortus zoonotic?
Yes, pregnant women should avoid contact with ewes during lambing season
What kind of bacteria is Corynebacterium spp?
Gram +
Cocci, club or rods (pleomorphic) → “Chinese Characters”
Non-spore forming
Non-motile
Facultative anaerobe

What test results will Corynebacterium spp have?
Catalase +
Oxidase +
Urease + (pathogenic members) → except C. bovis
What do the types of Corynebacterium renale cause?
C. renale (Type 1) → cattle, sheep, goats → cystitis, pyelonephritis, enzootic balanoposthitis
C. pilosum (Type 2) → cattle → cystitis, pyelonephritis
C. cystitidis (Type 3) → cattle → severe cystitis, rarely pyelonephritis
What characterizes the lesions of Corynebacterium spp?
Suppuration → make pus
How do blood agar plates compare between C. pseudotuberculosis vs. C. renale?
Why is there more pleomorphism and cocci forms of Corynebacterium spp in older cultures?
Lack of nutrients → slower metablism and shrinkage of rods
What is pyelonephritis?
Infection of kidneys
What causes the most severe form of cytitis in bovines?
C. cystitidis
What forms of Corynebacterium renale cause cystitis?
Any
What are contributing factors to C. cystitidis presence?
Stress of parturition
High-protein diet → increases pH of urine → ideal for colonization

Which kidney is a result of chronice vs. acute pyelonephritis from C. cystitidis?
Left → acute
right → chronic pyelonephritis
Signs of bovine pyelonephritis
First sign: bloody urine
Kicking at abdomen
Dysuria and arched back
Long-standing cases → renal damage
How is bovine pyelonephritis diagnosed?
Thickened ureters and enlarged kidney on rectal palpation
RBCs and protein in urine
C. renale in urinary deposits

Review
Top: C. pilosum (type 2) → dark yellow
Left: C. cystitidis (type 3) → white
Right: C. renale (type 1) → dull yellow

Tween 80 Medium
Top → C. cystidis → hydrolysis with Tween 80
C. renale and C. pilosum are negative
How is bovine pyelonephritis treated?
Antibiotic therapy
Penicillin → excreted in urine so very effective
What is Pizzle Rot also known as?
Ulcerative (enzootic) balanoposthitis
What species does Ulcerative balanoposthitis target?
Sheep, goats, cattle (esp. castrated males)
What pathogen causes Ulcerative balanoposthitis?
Corynebacterium renale
Pathogenesis of Ulcerative balanoposthitis
High protein intake → increase in urinary UREA
C. renale hydrolysis of urea → produces lots of ammonia
Ammonia irritates penis
What population is Ulcerative balanoposthitis more common in?
Castrated males
Symptoms of Ulcerative balanoposthitis
Swelling of prepuce
Difficulty urinating
Ulceration around preputial orifice → brown crust
If untreated, orifice can occlude

How is Ulcerative balanoposthitis treated and controlled?
Stop high-protein diet
Separate affected animals
Look at prepuce and make sure not obstructed → clip and clean fur
Tx: Penicillin and Cephalosporins
Testosterone Tx Q3 months